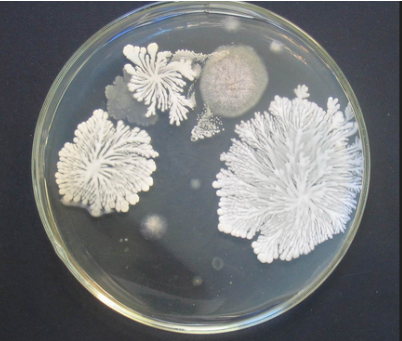

深圳亿博检测机构(EBOTEST)
扫码咨询
食品第三方检测
      亿博RoHS认证检测服务机构,可办理RoHS检测认证报告,拥有资质认可的实验室,有产品想获取RoHS报告可以咨询我们,服务热线:135-4327-2815
亿博检测机构(EBO)是服务全球的检验、鉴定、测试和认证机构,帮助众多行业和企业提供一站式的产品食品检测认证解决方案。
食品重金属检测亿博检测专业办理各种食品检测项目,EBO拥有众多优秀且专业的测试和认证工程师,可为广大食品厂商提供认证申请、标准咨询、测试、技术支持、对策、获得认证等“一站式”食品检测服务。
常见食品检测项目有重金属检测和微生物检测,如下详细介绍这两种食品检测内容:
1、什么是重金属?
重金属一般指比重大于4.0,且工业上常用的、对生物体有毒性的金属元素。如汞、镉、铅、铜和铬等。重金属在人体中累积达到一定程度,会造成慢性中毒。对人体毒害最大的有5种:铅、汞、铬、 砷、镉。这些重金属在水中不能被分解,人饮用后毒性放大,与水中的其他毒素结合生成毒性更大的有机物或无机物。 重金属有毒非金属物质:砷、氟、氰等。
2、食品重金属相关检测项目:
铅、镉、汞、砷、铬、锡、镍、氟、氰、稀土元素
3、食品重金属检测相关标准
《食品中污染物限量》GB2762-2012
《食品中污染物限量》GB2762-2005
《食品中污染物限量》GB2762-2005 中关于取消硒指标的公告
《食品中铝的测定 电感耦合等离子体质谱法》GBT 23374-2009
食品微生物检测
1、什么是微生物?
微生物是一切肉眼看不见或看不清的微小生物,其往往个体微小,结构简单,通常要用光学显微镜和电子显微镜才能看清楚的生物。 微生物一般划分为8大类:细菌、病毒、真菌、放线菌、立克次体、支原体、衣原体、螺旋体。 微生物的化学组成主要以C,H,O,N,P,S及其他元素。 微生物性食物中毒一般分细菌性和真菌性食物中毒。 细菌性食物中毒是指进食含有细菌或细菌毒素的食物而引起的食物中毒。在各类食物中毒中,细菌性食物中毒最多见。其中又以沙门氏菌、金黄色葡萄球菌最为常见,其次为蜡样芽胞杆菌。细菌性食物中毒发病率较高而病死率较低,多发生在气候炎热的季节。 真菌性食物中毒(fungousfoodpoisoning)是指由于食入霉变食品引起的中毒,近年来这方面的报道渐多有些是急性中毒,死亡率极高;有些是慢性中毒,可发生癌变目前已引起全世界的广泛重视。
2、食品微生物相关检测项目
5日生化需氧量、菌落总数、大肠菌群、大肠杆菌、粪大肠菌、耐热耐酸菌、军团菌、金黄色葡萄球菌、沙门氏菌、志贺氏菌、嗜热菌芽孢、放线菌、溶血性链球菌、霉菌与酵母菌、单核细胞增生李氏特菌、绿脓杆菌、沉降菌、浮游菌、乳酸菌、抑菌性能菌、布鲁氏杆菌、阪崎肠杆菌
3、食品微生物检测相关标准
《食品微生物学检验 菌落总数测定》GB 4789.2-2010
《食品微生物学检验 大肠菌群计数》GB-4789-3-2010
《食品微生物学检验 沙门氏菌检验》GB-4789-4-2010
《食品微生物学检验 金黄色葡萄球菌检验》GB-4789-10-2010
《食品微生物学检验 霉菌和酵母计数》GB-4789-15-2010
《食品微生物学检验 乳与乳制品检验》GB-4789-18-2010
《食品微生物学检验 单核细胞增生李斯特氏菌检验》GB-4789-30-20
《食品微生物学检验 乳酸菌检验》GB-4789-35-2010
《食品微生物学检验 阪崎肠杆菌检验》GB-4789-40-2010
《食品微生物学检验 总则》GB-4789-1-2010
有产品办理检测认证或想了解更多详情资讯,请联系亿博检测中心田小姐:13530187180,QQ2355407926
本文连接:http://www.foodstest.cn/spaqjc/929.html
相关文章


